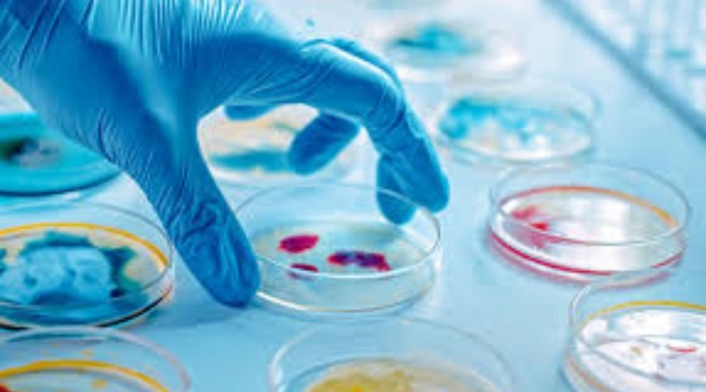

Las cinco carreras que darán los mejores sueldos en el futuro, según Harvard
Hay carreras que tendrán un gran impacto en el futuro debido al alcance de la tecnología y el cambio climático.

El mercado laboral está en constante evolución, y hay muchas carreras que serán mejor remuneradas en el futuro con respecto a otras por cuenta de factores como el avance de la tecnología o el cambio climático que atraviesa el mundo.
En este sentido, todas aquellas que están asociadas a este campo son las que recibirán el mejor sueldo a raíz de la constante interacción que tienen las personas con los dispositivos tecnológicos. Esta es precisamente una proyección que realiza la Universidad de Harvard frente a las profesiones más lucrativas para el año 2040.
Le puede interesar: Estas son las cinco universidades que más garantizan empleo en Colombia en 2025
De acuerdo al análisis realizado por Harvard, las carreras universitarias que están relacionadas a la ingeniería y a la robótica son las que garantizarán los salarios más altos en los próximos años, ya que tendrán una mayor adaptación al avance de la inteligencia artificial y el cambio climático. Estas son.
Big Data
Según explica la Universidad de Harvard, la Big Data será una de las carreras mejor remuneradas en el futuro ante la necesidad de contar con alternativas para que el almacenamiento y el procesamiento de grandes cantidades de datos sea más accesible, rentable y compatible con el medio ambiente.
Por otra parte, muchas empresas también consideran fundamental tener esta información de primera mano con tal de conocer mejor a su público objetivo y tomar mejores decisiones con base en ello.

Biotecnología
La tecnología contribuye de manera significativa en el desarrollo de la atención médica ante la precisión que pueda brindar en el tratamiento de enfermedades como el cáncer o el alzheimer. Esta circunstancia hará que la labor de los profesionales en biotecnología sea bien valorada en el futuro.
Y es que la colaboración entre la salud y las herramientas tecnológicas permitirá la edición de terapias genéticas y controlar la administración biológica de medicamentos por medio de la asistencia de una máquina.
Más noticias: Ranking mundial puso a dos colegios de Colombia entre los 10 mejores del mundo
Robótica
Tal como sucede con la biotecnología, la robótica también será valorada en el futuro, ya que las empresas invierten recursos en contar con herramientas que faciliten las gestiones que llevan a cabo muchas personas en su vida cotidiana.
En este caso, esta carrera incluye procesos como el diseño, programación y optimización de los robots para que puedan cumplir con unas tareas determinadas.

Blockchain
El blockchain literalmente traduce "cadena de bloques". Y es que esta actividad permite garantizar una mayor seguridad informática al constituir una base de datos en la que la información está almacenada en bloques, ligados entre sí de manera criptográfica, para que haya una mayor accesibilidad.
Según explica Harvard, esta profesión también tendrá una buena remuneración por la transparencia que pueda generar en los negocios teniendo en cuenta la accesibilidad a los datos en un mundo interconectado.

Más noticias: Tres universidades colombianas están entre las 20 mejores de Latinoamérica, según ranking mundial
Ciberseguridad
Al igual que en el caso anterior, la ciberseguridad también será altamente valorada en el futuro a raíz de la importancia que tiene la conservación de la información por parte de las empresas, por lo que es importante protegerla ante los riesgos que pueda generar un ataque informático.
Por otra parte, esta necesidad también tiene un marco legal. Por ejemplo, la Ley 1581 de 2012 obliga a proteger la información de los colombianos en archivos y bases de datos, tanto públicos como privados.

Además de los casos anteriormente mencionados, Harvard también le da importancia a las habilidades de Agile Coach y Scrum Master, ya que estas serán fundamentales en las empresas para impulsar la creatividad y la capacidad de liderazgo, así como la paciencia y la comunicación.